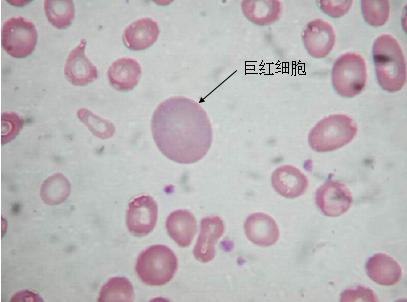
关于贫血诊断,贫血知识普及

近些年随着生活水平的提升
老百姓的饮食条件也变得越来越好
然而贫血症状的人却越来越多
在日常生活中贫血是我们很常见的病症

贫血已经成为日常中最常见的病症
都说,贫血是营养不良
“吃点补充营养的食品”就好了
但是事实真的是这样吗
相关数据显示
全球大约有超过15~16亿人受贫血影响
尤其女性朋友因为自身生理原因
更容易发生贫血
头晕、乏力、困倦、嗜睡等

贫血导致的头晕、乏力
会经常被人说:气色不好
如果你也发生贫血病症时
你会发现自己平时容易出现
头昏脑胀、气色不好

贫血导致的气色不好。头昏脑胀
长此以往
搞不好还会变成黄脸婆
那么你觉得怎么才算是真正的贫血呢
而当你确定自己贫血了
又应该怎么解决
今天龙垚小辉就来为大家来答疑解惑
上述我们说到这些症状,都是属于贫血的常见病症,是血液携带氧气能力降低,低于正常范围下限的一种病症。一般来说成年男性血红蛋白小于120g/L,成年女性血红蛋白小于110g/L,即是贫血。

人体内的血红蛋白
也许你对贫血有一定的误区,觉得是小事情,不予重视。其实贫血对人体的伤害很大,严重还会出现晕厥、食欲不振、脏器功能减退等症状。在生活中一旦出现贫血,应该怎么吃什么,怎么补。
贫血是什么
有很多人认为贫血是因为血量丢失
但真正由于血量丢失
而导致贫血的病例
只占了贫血中很小的一部分
·
·
贫血是一种症状,真正意义上并非是一种独立的疾病,而是一种临床上病症。
根据病因、发病原理可以分为红细胞减少性贫血、溶血性贫血、失血性贫血。
- 红细胞减少
主要是指体内红细胞所需要的造血原料在减少或者吸收不足,从而影响红细胞的生成,致使贫血。一般在日常生活中常见的有缺铁性贫血、吸收障碍性贫血。
- 红细胞丢失或者破坏

红细胞遭到破坏
一种原因可能是因为红细胞本身在人体内存在自身的缺陷;第二种外界环境造成的影响,导致红细胞在人体内受到伤害。(如:女性经期的大量出血、经常性鼻出血患者、孕妇分娩时的大出血)
正常情况下每年应该定期到医院做全省体检,像贫血在检查血常规时是很容易被发现的。如果发现贫血时,应该预约医生做进一步的检查,医生会通过咨询以往的病史资料,结合体检的血常规等其他检查明确贫血的真正病因和类型。在确定病因之后可以选择相应的就诊科室:血液科、营养保健科、肿瘤科、消化科、肾病科等。
三种情况应该尽早查明
- 长期不明的慢性病习惯贫血

病毒准备侵入
人体内有着多种不同的造血因子,它能够直接或者间接的参与到造血的过程中。造血干细胞容易遇到一些聪明的敌人,比如病毒,它会扰乱人体的整个免疫系统,从而让白细胞思想混乱,把自己的妈妈造血干细胞也列入消灭名单。使得造血干细胞被消灭,没了造血干细胞,自然就没有足够多的红细胞生成,使得红细胞数长期低于正常值,即属于慢性病性病因。
- 长期恶化的轻度贫血

人体内癌细胞移动和扩散过程
人体中的营养输送需要血液的负责,而人体出现病毒或者癌细胞时会消耗人体内大量的血液进行扩散。所以人体内的病毒和癌细胞越多,人自身的贫血病症就会越高。当贫血程度越高之后,癌细胞也会持续恶化下去,加速人体机能的衰退。
- 贫血+伴随症状
当你发现自己贫血时伴随着以下的几种,应该及时就医治疗。
头昏、头疼、耳鸣、昏厥、肌乏力、恶心呕吐、食欲不振、大便出现黑色柏油样等症状。
找准病因和类型
前面我们说到贫血
不是一种独立的疾病,是一个病症
虽说只是一种病症
但是严重的贫血甚至能导致死亡
只有找准病因和类型
根据具体病症才能有效根治贫血
·
·
- 缺铁性贫血

缺铁性贫血
红细胞的生成也是需要一定的营养原料,在其中最重要的一样就是铁。缺少铁就到缺铁性贫血,这种也是我们生活中最常见的。
- 巨幼细胞贫血
巨幼细胞贫血
除了需要铁,也要适量的补充维生素B12、叶酸等物质来促进红细胞的发育和成熟。如果长期不重视这些物质的摄入,就会导致红细胞在体内的发育不良,就会造成巨幼细胞贫血。
- 再生障碍性贫血

再生障碍性贫血
人体的造血干细胞遭到外界环境或者病毒的侵害导致死亡,无法及时的造出人体所需的红细胞。这种就叫做再生障碍性贫血,绝多数人认为这是因为人体的免疫系统出问题造成的。
哪些人群更应该注意贫血
- 老年人

退休老年人注意保持良好心态
根据我国的数据统计,在59~69岁的老年人群体中,贫血的发病率约35%,而随着年龄越大发病率也越高。
- 孕妇和女性

孕妇出现呕吐现象
在孕期带来的一些生理现象,怀孕早期的孕吐,会导致血液中血红蛋白的降低。在经期的女性也会因为出血过多而导致贫血。
- 婴幼儿

婴幼儿添加辅食吸收营养
婴儿在生长发育的过程中需要更多的营养物质,他们只能通过母乳或者奶粉吸收营养,如果只采用奶粉喂养的婴儿长期可能会导致缺铁性贫血,所以新手妈妈在喂养婴幼儿时应该记得适量增加辅食来帮助吸收营养。
对号入座找准的治疗方向
- 药物治疗
铁剂:通过铁剂摄入可以补充造血干细胞所需的营养原料,可以有效的改善缺铁性贫血。在日常中常见的药物有硫酸亚铁、葡萄糖酸亚铁等。

人体所需的Fe元素
细胞因子:通过这些因子的吸收可以刺激造血干细胞的分化,提*干高**细胞的造血功能。
- 手术治疗
可以通过移植造血干细胞使患者的造血功能得以恢复,主要适合治疗急性再生障碍性贫血。

自体造血干细胞移植
可以通过相同血型的输血,通过输血可以提高人体内的血容量,主要用于治疗急性出血引起的贫血和再生障碍性贫血。
- 日常预防

含铁元素的食物
对于长期喜欢饮用浓茶、咖啡等产品的人群,应该要控制每日的饮用量或者直接戒掉饮用这类产品用温水替代。注意定期到医院体检,及时补充营养元素,吃一些含铁量元素高的食物,如菠菜、瘦肉、木耳的等。